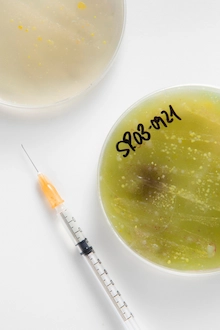
Microscopic Diagnostics

Teratozoospermia
Teratozoospermia, a condition affecting male fertility, occurs when a high percentage of a man’s sperm have abnormal shapes or structures.
In simpler terms, the sperm cells, which are essential for successful fertilization, have irregular shapes that hinder their ability to penetrate the egg. This condition can be a source of great concern for couples aspiring to start a family.
The first step in treating Teratozoospermia is a thorough diagnosis. Our experienced doctors utilize state-of-the-art diagnostic tools to assess the extent of the condition and determine the most suitable treatment plan tailored to your needs.
Understanding Teratozoospermia
Teratozoospermia can be attributed to various factors. Through a comprehensive evaluation, we address the root causes including:
Genetic abnormalities and hormonal imbalances that affect sperm morphology.
Exposure to toxins, excessive alcohol consumption, or smoking habits.
Infections, testicular trauma, or certain medications that hinder structure.
Teratozoospermia Treatment in Chennai
At our cosmetic clinic, we offer advanced and personalized treatments to address this condition effectively:
IUI is often the first step for mild to moderate cases. The healthcare provider separates healthy sperm from abnormal ones and introduces them directly into the uterus during ovulation, bypassing the cervix to enhance fertilization prospects.
A more intricate procedure for severe cases. Ovaries are stimulated to produce eggs, which are retrieved and fertilized outside the body with healthy sperm. The best-quality embryo is then selected and implanted into the uterus.
An advanced form specifically targeting severe morphology issues. A single healthy sperm is manually selected and directly injected into the egg. ICSI has remarkably high success rates for overcoming structural challenges.
Pre & Post-Operative Care
Pre-Operative Guidelines
Maintain a healthy lifestyle through regular exercise, a balanced diet, and avoiding smoking/alcohol. Attend pre-operative counseling to understand potential risks and care instructions.
Post-Operative Support
Follow prescribed medications diligently, abstain from sexual activities for the specific recommended period, and attend all follow-up appointments. Emotional support from loved ones is vital during recovery.

Your Dream of a Family Starts Here
Expert Intervention
With advancements in medical science and expert providers in Chennai, effective treatments are available for you.
Compassionate Support
With the right support and proper treatment, the dream of starting a family can indeed become a reality.
